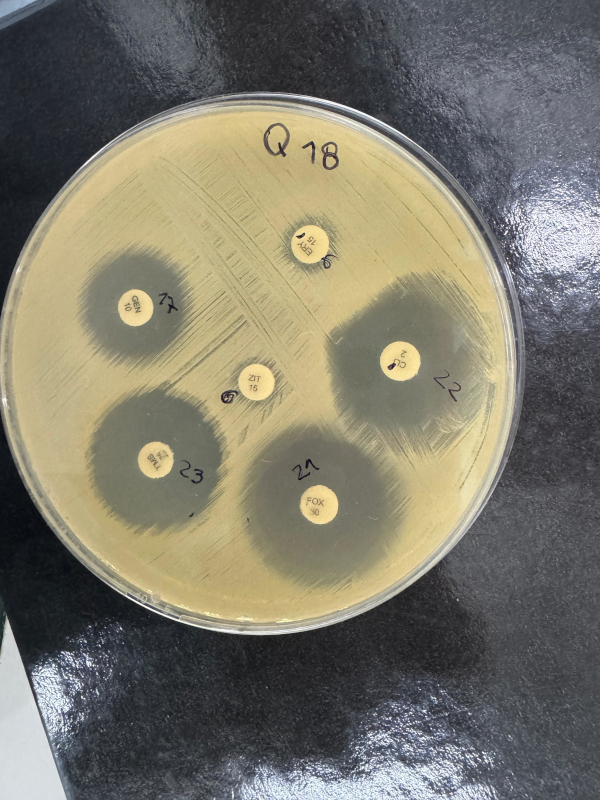

Un instituto que investiga sobre bioconstrucción, eficiencia energética y cuidado ambiental
Facultad de Ingeniería
Un instituto que investiga sobre bioconstrucción, eficiencia energética y cuidado ambiental
Por Andrés Perrone
Este espacio de la Facultad de Ingeniería se consolida como un pilar fundamental para la vinculación tecnológica, la investigación aplicada y la prestación de servicios especializados a la comunidad.
Desde la Facultad de Ingeniería de la Universidad Nacional de Misiones (UNaM), el trabajo articulado a través de sus laboratorios y el recientemente creado Instituto de la Facultad de Ingeniería (IFI) se ha consolidado como un pilar fundamental para la vinculación tecnológica, la investigación aplicada y la prestación de servicios especializados a la comunidad regional.
La unidad académica se caracteriza por desarrollar una gran cantidad de servicios a terceros, que se implementan a través de sus nueve laboratorios activos. Estas actividades complementan los proyectos de investigación y extensión que se vienen ejecutando en la provincia de Misiones y alrededores, siempre con un enfoque en proyectos de gran demanda y de carácter netamente aplicado.
“Nos caracterizamos por trabajar justamente en proyectos con gran demanda y la particularidad que tienen de ser aplicados”, destacó el ingeniero Alejandro Kerkhoof desde la Secretaría de Ciencia Técnica. Este esfuerzo es posible gracias a un cuerpo de profesionales formados en la propia casa de estudios, que han continuado su especialización a través de maestrías y doctorados, construyendo una expertise específica.

La creciente infraestructura y la adquisición de equipos de alta tecnología, inaccesibles para la mayoría de las empresas locales, son la base que sustenta esta interacción fructífera entre la investigación y la extensión. Este ecosistema propició en 2021 la creación del IFI, un hito institucional que articula y es el paraguas para todos los laboratorios de la facultad, dotándolos de una estructura de gobernanza propia con director y codirector.
El área técnica del instituto maneja tres ejes principales de trabajo:
- Materiales de construcción y suelos: Se evalúan tanto materiales convencionales (hormigones, aceros, maderas) como otros de carácter orgánico para bioconstrucción y aquellos derivados de la economía circular, como plásticos y vidrios reciclados de uso no alimenticio. El área de estudios de suelos cuenta con una trayectoria de casi 20 años.
- Eficiencia energética y optimización de sistemas industriales: Equipos de trabajo se especializan en diagnósticos de eficiencia energética y mejora de capacidades instaladas en baja, media y alta tensión, así como en la optimización de equipos industriales.
- Evaluación y monitoreo ambiental: Se realizan mediciones de parámetros y diagnósticos sobre contaminación en ambientes laborales y urbanos, en interacción con empresas, municipios y la comunidad.
Vinculación concreta con el medio
Un ejemplo emblemático de esta vinculación es el trabajo con el municipio de Oberá. Allí, se participó en la puesta en valor de la “Casa Boldú”, se capacita al personal de la dirección de obras públicas y, de manera colaborativa, se avanza en la construcción de un banco de ensayo para postes de hormigón pretensado para líneas de distribución eléctrica.
“Este hito es importante porque involucra a las carreras de Ingeniería Civil e Ingeniería Electromecánica”, explicó Javier Duarte, director del IFI. Además, en el área de

extensión, se promueve la capacitación en construcción y tecnología para mujeres en situación de vulnerabilidad y se brinda formación a estudiantes en herramientas digitales actuales.
Cómo acceder a los servicios
Los servicios se activan mediante pedidos de empresas, ONG, cooperativas u organismos, que pueden contactarse a través de los correos disponibles en la página web de la Facultad de Ingeniería o mediante los docentes e investigadores. Una vez recibida la solicitud, el Instituto o la Secretaría de Ciencia Técnica la derivan a los laboratorios con la expertise específica, quienes elaboran un presupuesto para llevar adelante el servicio.
“Nos sentimos muy orgullosos del personal que disponemos, tanto docente como no docente, que nos permiten llevar adelante todas estas acciones”, afirmaron. “Todo lo que tenemos aquí es parte de lo que la universidad hizo. Tenemos equipos industriales que no se tienen en el medio, y es por eso que damos ese salto que el empresario o nuestros graduados no pueden hacer solos, porque son equipos muy costosos. Pero en el campo de la investigación, la vinculación y la transferencia, su impacto es significativo”.
Leer más…Un instituto que investiga sobre bioconstrucción, eficiencia energética y cuidado ambiental
- Visto: 39